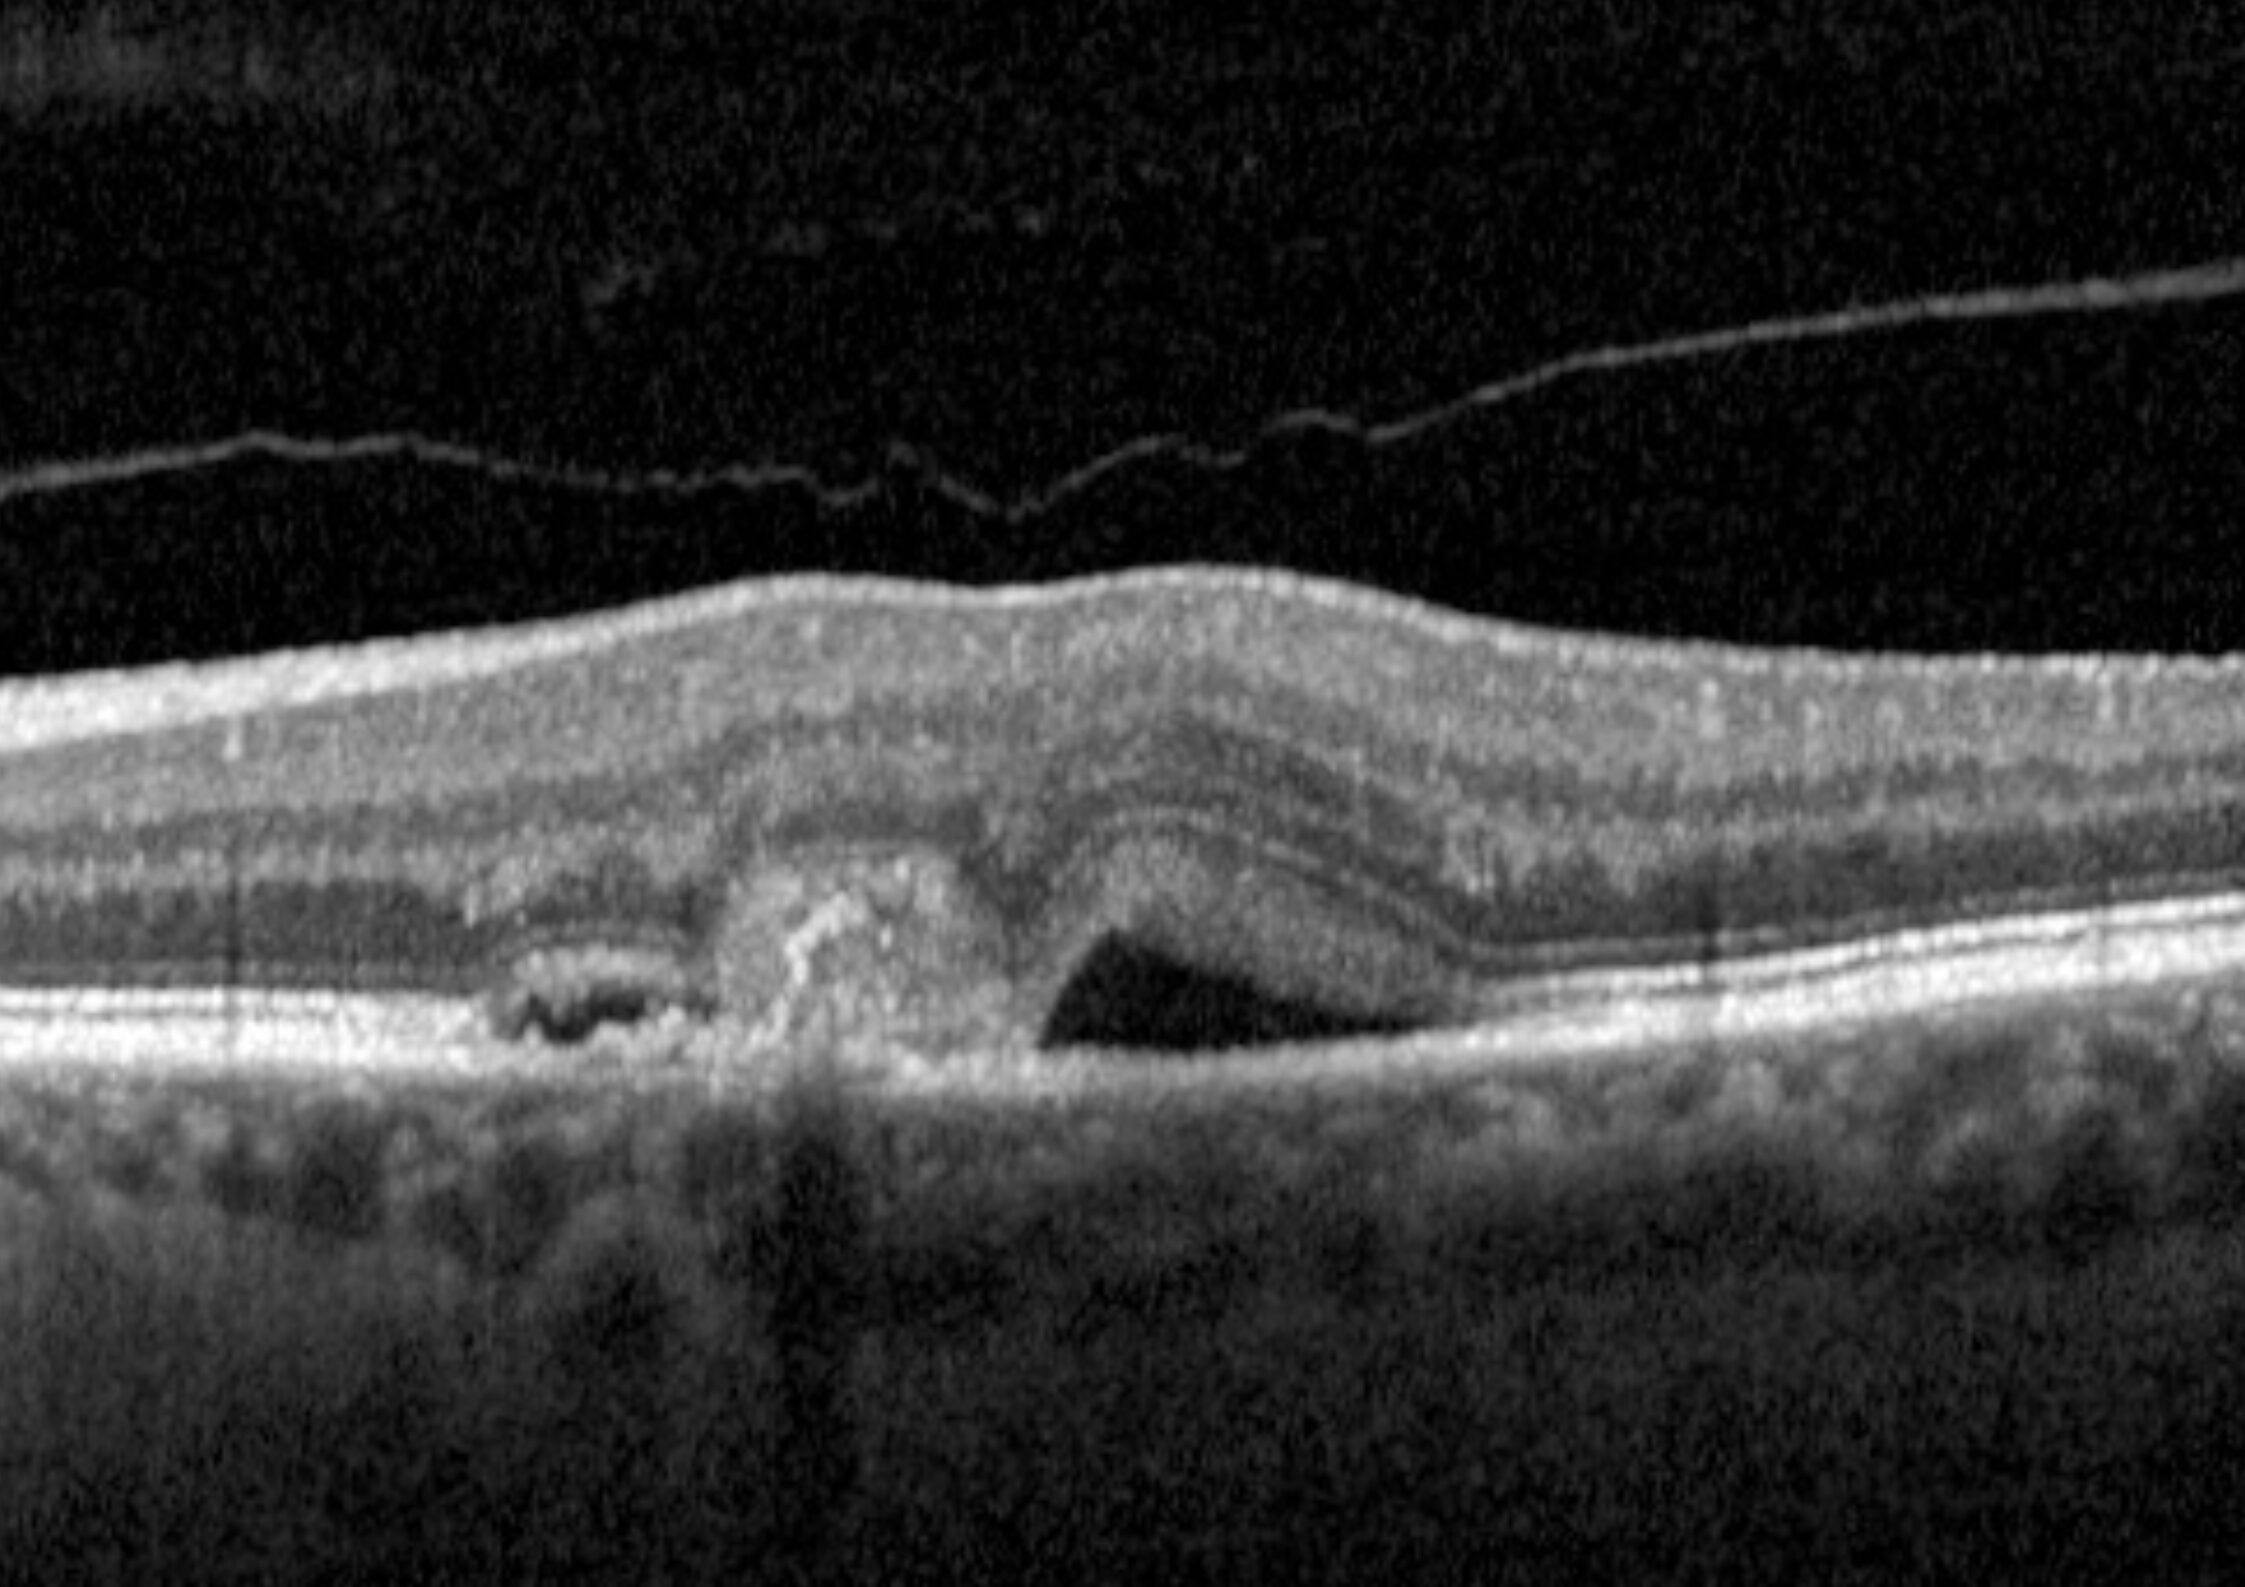
Iniezioni intravitreali

Iniezioni intravitreali

Cosa sono le iniezioni intravitreali?
Le iniezioni intravitreali sono un trattamento medico minimamente invasivo che viene utilizzato in oculistica per somministrare farmaci direttamente nell’occhio, più precisamente a livello del vitreo, ossia quella sostanza gelatinosa che riempie la parte posteriore dell’occhio.
Fino a pochi anni fa il destino del paziente a cui veniva diagnosticata una maculopatia essudativa era quello di andare incontro ad un progressivo ed irreversibile deterioramento della propria funzione visiva, non esistendo terapie efficaci. La recente introduzione di farmaci biologici che agiscono a livello dei meccanismi biochimici che sono alla base dello sviluppo di queste forme di maculopatia ha rivoluzionato completamente il trattamento di queste patologie. Sebbene a volte si tratti di forme aggressive questi farmaci possono rallentarne la progressione, migliorando l’acuità visiva finale di questi pazienti.
Il vantaggio principale delle iniezioni intravitreali è l’azione mirata e localizzata in quanto consentono di somministrare il farmaco direttamente nella sede interessata, ossia la retina, evitandone la diffusione sistemica.
Indicazioni
Le iniezioni intravitreali sono comunemente utilizzate per trattare molte patologie che coinvolgono fondamentalmente la retina, come ad esempio:
- Maculopatia essudativa
- Edema maculare diabetico
- Occlusioni venose retiniche
- Retinopatia diabetica proliferante
- Uveiti posteriori.
Farmaci comunemente utilizzati
I farmaci che possono essere somministrati attraverso questa procedura sono sostanzialmente:
- Farmaci anti-VEGF: questi farmaci sono costituiti da anticorpi monoclonali o proteine di fusione ed hanno la capacità di bloccare selettivamente il VEGF, (Vascular Endothelial Growth Factor), ossia il principale fattore di crescita che stimola lo sviluppo di nuovi vasi sanguigni in alcune condizioni patologiche. Questi nuovi vasi però presentano molte anormalità, hanno spesso una crescita disorganizzata e sono caratterizzati da pareti vascolari sottili, che provocano intensi fenomeni essudativi. Tutti questi nuovi farmaci sono in grado di inattivare il VEGF, arrestando lo sviluppo di nuovi vasi e favorendo la regressione di quelli già esistenti. I principali farmaci che vengono utilizzati in oftalmologia sono Bevacizumab (Avastin®), Aflibercept (Eylea®), Brolucizumab (Beovu®) e Faricimab (Vabysmo®). Ognuno di questi farmaci presenta alcune peculiarità e quelli di nuova generazione sono in grado di bloccare anche altri fattori di crescita oltre al VEGF, potenziandone l’effetto antiangiogenetico
- Corticosteroidi: questa classe di farmaci, il cui utilizzo è molto diffuso in medicina, vengono utilizzati comunemente per ridurre l’infiammazione, in questo caso a livello retinico. Il principale farmaco che viene utilizzato in oculistica è il desametasone a rilascio prolungato (Ozurdex®).
Procedura
Si tratta di una procedura ambulatoriale, della durata di pochi secondi e nella maggior parte dei casi l’iniezione non è dolorosa. Prima della procedura vengono instillate delle gocce di anestetico e viene posizionato un blefarostato, ossia una piccola molla che mantiene aperto l’occhio. Dopodiché il medico applica un collirio disinfettante e procede all’iniezione, utilizzando un sottile ago per pungere a livello della sclera, ossia la parte bianca dell’occhio.
Terapia post-operatoria
Dopo l’iniezione il paziente potrà tornare tranquillamente a svolgere le normali attività della vita quotidiana. Tuttavia è importante seguire attentamente le indicazioni del medico ed instillare correttamente i colliri che verranno prescritti. Solitamente vengono utilizzati un antibiotico ed un antisettico per prevenire eventuali sovrainfezioni batteriche a livello del sito di iniezione del farmaco.
Vantaggi
Questi farmaci rappresentano l’unica terapia al momento esistente per il trattamento della maculopatia essudativa e dell’edema maculare. I principali effetti dell’inibizione del VEGF sono:
- Regressione dei neovasi patologici
- Riduzione dell’edema retinico
- Riduzione del rischio di complicanze
- Rallentamento del deterioramento della funzione visiva.
Il recupero visivo è molto variabile e dipende in gran parte dalla cicatrice che i neovasi, una volta regrediti, lasciano a livello retinico.
Soprattutto nei casi avanzati tale recupero può essere limitato. In questi casi capita che il paziente si chieda la ragione di proseguire con le iniezioni. Il principale motivo per cui è importante però continuare il trattamento è quello di bloccare un’ulteriore crescita dei neovasi patologici e favorirne una, seppur parziale, regressione, aiutando a conservare il più possibile l’acuità visiva del paziente.
Durata e frequenza delle iniezioni
Nella maggior parte dei casi non è sufficiente una sola iniezione ma, trattandosi di patologie croniche, sono necessari cicli di iniezioni ripetute ad intervalli di 4-8 settimane. Le membrane vascolari infatti tendono a rispondere bene alle iniezioni intravitreali ma a volte possono riattivarsi, anche a distanza di molto tempo, richiedendo quindi un ulteriore trattamento.
Esistono vari regimi di trattamento ma quello che ha dimostrato la maggiore efficacia nella riduzione della progressione della maculopatia è il cosiddetto “treat and extend”. Questo protocollo prevede una dose iniziale di 3-4 iniezioni, ciascuna a cadenza mensile, dopo le quali viene progressivamente aumentato l’intervallo tra le somministrazioni, fino alla stabilizzazione dell’acuità visiva.
Complicanze
Le iniezioni intravitreali sono ormai una pratica clinica molto diffusa e molto sicura. L’effetto collaterale più frequente è il rossore oculare, che può durare qualche giorno, e nella maggior parte dei casi è provocato ai colliri antisettici che vengono utilizzati prima della procedura.
A volte il paziente può avvertire un temporaneo offuscamento della vista, causato dalla disgregazione del vitreo in seguito all’iniezione del farmaco.
Raramente si può osservare un aumento della pressione intraoculare, soprattutto se si utilizzano corticosteroidi, che tende a risolversi nel giro di qualche settimana.
Le complicanze gravi, come infezioni o danni retinici, sono rare.
